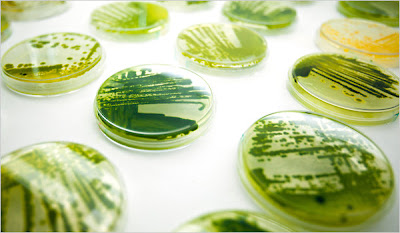

Hope you had a great week lovelies!
Here is what happened at Chic ‘n Cheap Living this week:
– Photo Love – Unexpectedly sowing hope
– Chic ‘n Cheap Living Contest: Kick off your spring wardrobe and enter to win anything from J.E.M. Apparel!
– Are chairs just chairs or is there one that really shows off your personality?
– Bookworms and fashionistas unite with Kate Spade’s book of the month clutches!
– Sale time at the Outnet!
– Links à la Mode – March 24th
Here are some worthy reads from blogger buddies and beyond:
– Actors as artists? Yes when it comes to raising money for the Winnicott Foundation Ball – Jude Law’s work below raised £1000 for premature/sick baby units
– Algenist, a new beauty line meant to protect aging skin comes to life in another round of sea matter becomes a cosmetic item – would you try it?
– Tangerine is one of this season’s hottest colors – would you wear it?
– Couture Carrie always selects such fun outfits – now she selects her favorite picks if she had a million dollars (ooh imagine if you had a $1 million shopping spree – would you buy this Dolce & Gabbana dress like me?)

Fabulous post, darling!
Thanks for the mention!
xoxox,
CC
I would definitely wear tangerine; such a fun color!
Tangerine trend is definitely perfect for this summer!
i’m so into it 🙂
THE SECRET LIFE OF “D”
in Love&Light
Queen D
lovely orange dresses!!
<3 steffy
steffysprosandcons.blogspot.com
I would definitely wear Tangerine!!! I bought a v-neck cotton sweater from J Crew and the color is “Cerise” (basically, orange) and I get a lot of compliments when I wear it.
Oh yes! My dreams are filled with the color of Tangerine … Again congrats on Links a la Mode 🙂
from © tanvii.com
loving the jude law photo.. so awesome! miss your blog. sorry to be such a bad friend! hope all is going well.. xoox
Love that tangerine color is in style!
Eternally yours,
Stephanie
i have been loving tangerine!! it’s such a fun pop of color right now 🙂
Nice post, and I really like the tangerine color. I’d definitely wear it in spring. 🙂
Thanks for stopping by my blog too
-Dale
Tangerine looks good on a lot of skintones. Following your blog!
That last dress is beautiful!
http://fashuhneestah.blogspot.com/
yes! love tangerine and can’t wait to find some pieces!
rockoomph.blogspot.com
I love the tangerine – what a fun color! Orange is not one of the best shades on me, but I still think it’s really fun!
I would definitely wear tangerine. I’m already into coral and much of the coloring used in the new spring pieces with the Ann Taylor Loft.